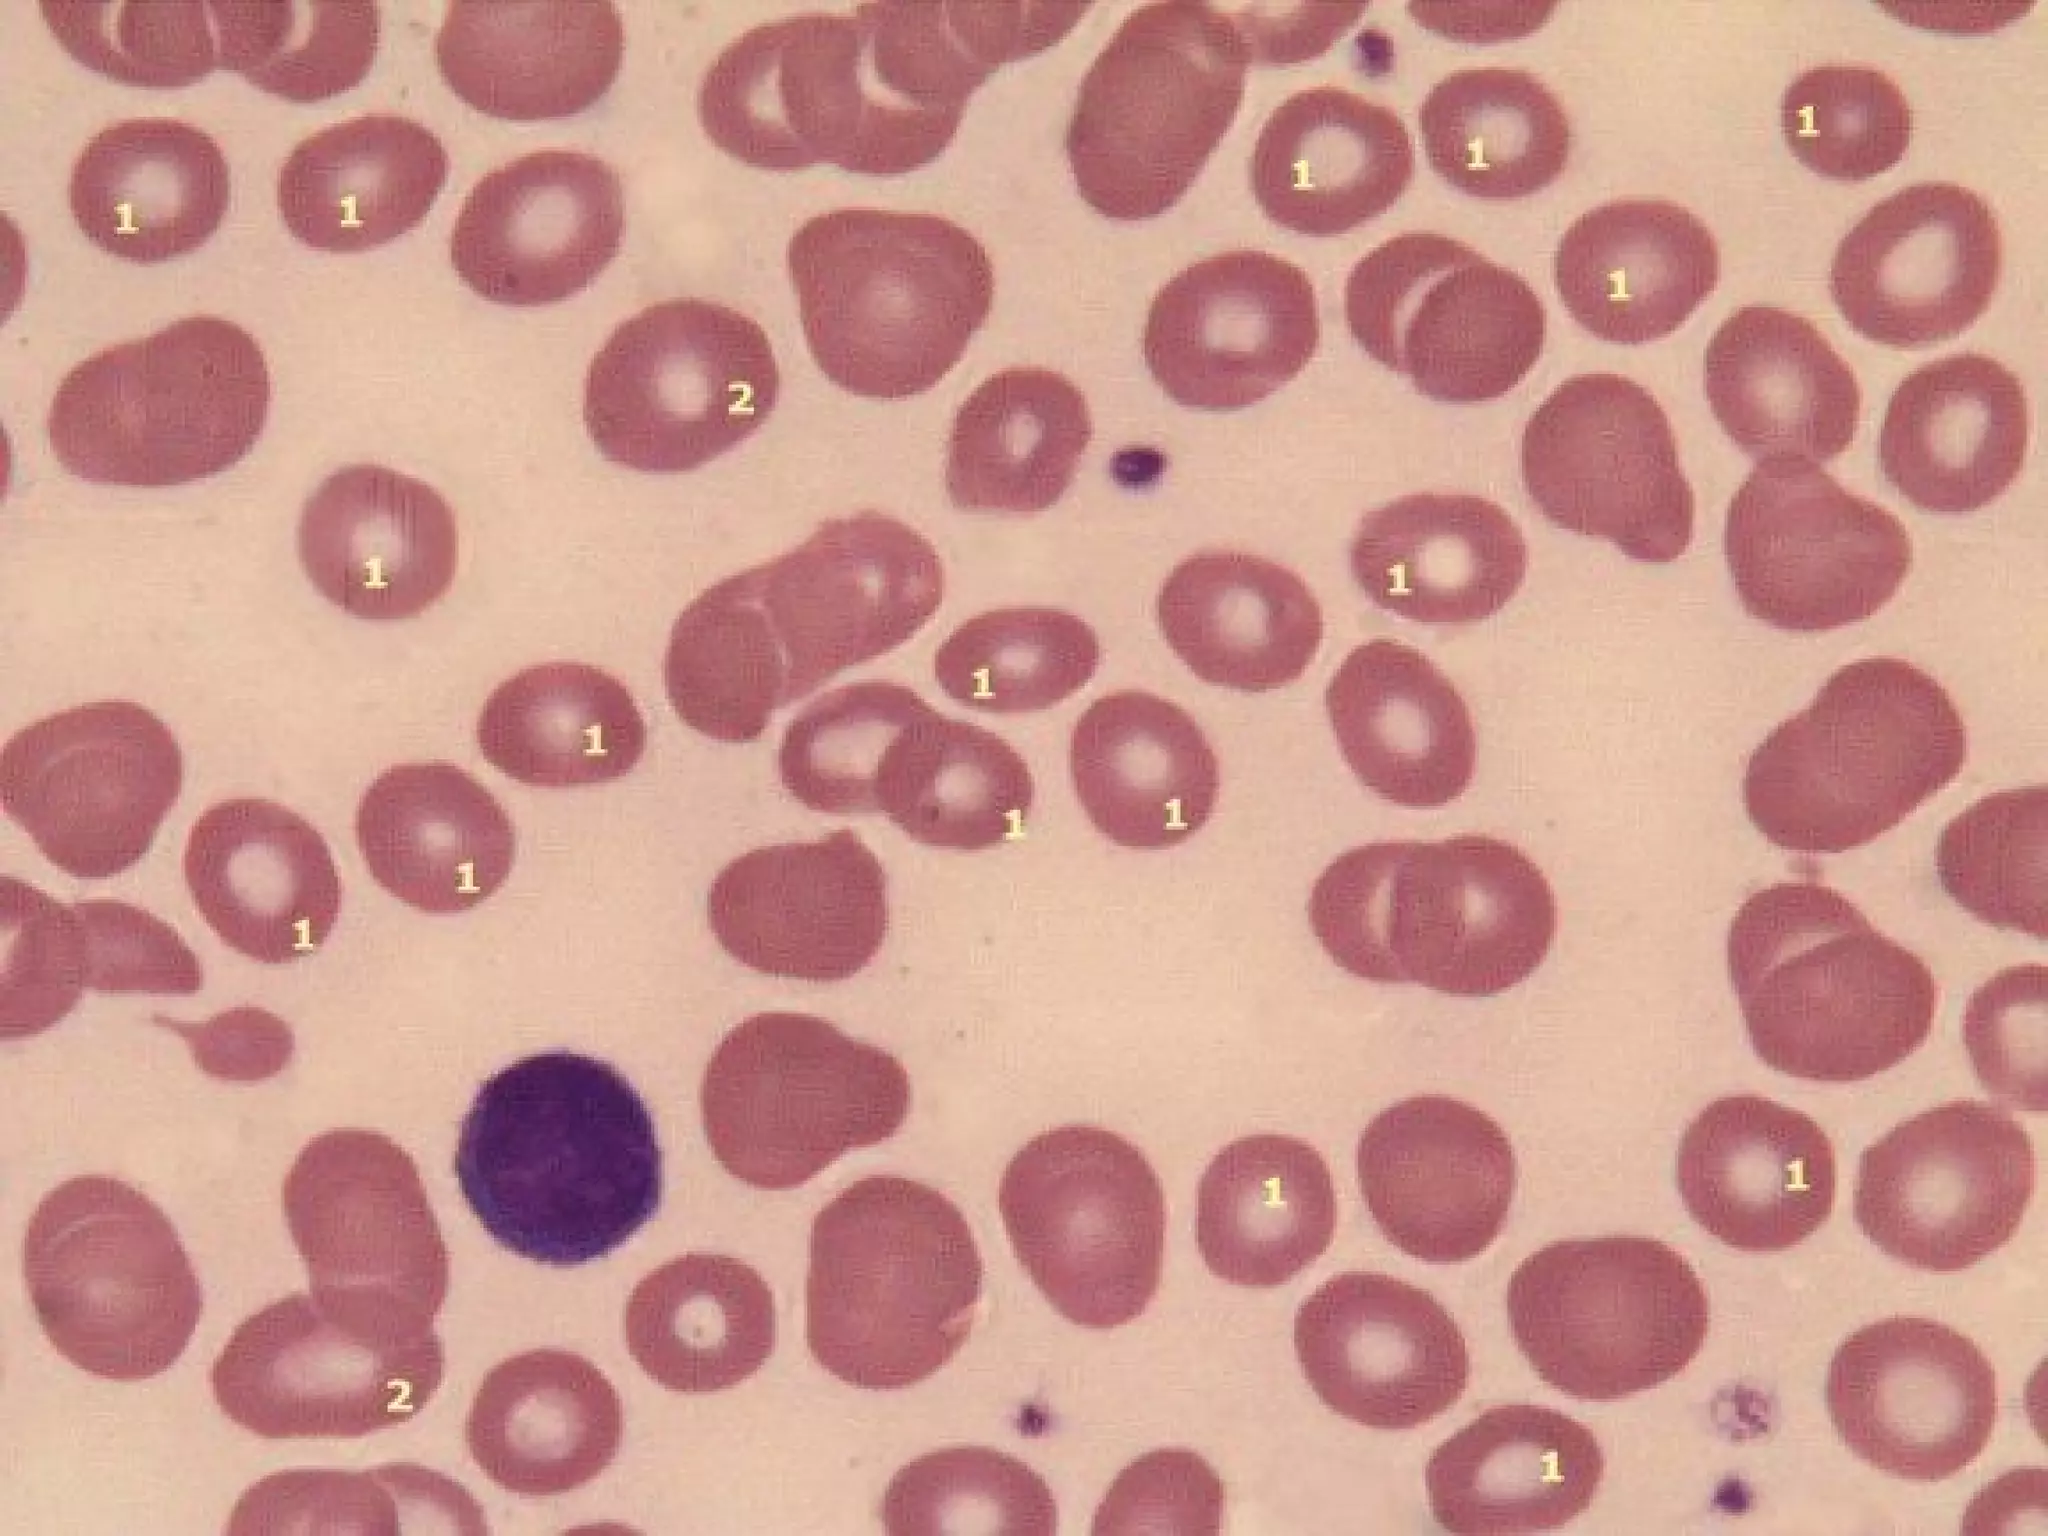

Este documento describe las diferentes etapas de maduración del eritrocito y las anormalidades morfológicas que pueden presentarse, incluyendo cambios en la forma, tamaño e inclusiones anormales, así como variaciones en la distribución y color de los eritrocitos. Explica las características morfológicas de diferentes tipos de células anormales como poiquilocitos, drepanocitos, esferocitos y otros, además de las posibles causas patológicas asociadas a cada una.